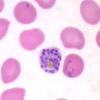

Plasmodium (malaria) Flashcards
(54 cards)
Agente etiológico de la malaria
Plasmodium sp.
Es el tipo de plasmodium más frecuente a nivel global
Plasmodium falciparum
Es el tipo de plasmodium más frecuente en México
Plasmodium Vivax
Malaria es una enfermedad transmitida por
vector (mosquito)
¿Que es el cinturón de la malaria?
Son las zonas tropicales endémicas para malaria e incluyen a LatinoAmerica, Africa Sub-Sahara, Sur y Sureste de Asia
De los 100 tipos de malaria sp. que existen, ¿cuales son los que infectan a los humanos?
P. falciparum, P. vivax, P. malariae, P. ovale, y P. knowlesi
Es el mecanismo por el cual P. vivax infecta los eritrocitos del huesped
Mediante la unión al antígeno eritrocitario “duffy”
Es una condición clínica por la cual se confiere protección contra malaria
Anemia por células falciformes
¿por que la anemia por células falciformes es un factor protector para malaria?
Por que los eritrocitos en hoz característicos no cuentan con el antígeno “duffy”, y plasmodium no puede entrar a la célula
¿Cuales son otras dos enfermedades que hacen al huesped menos susceptible a complicaciones por malaria?
Deficiencia G6PD, y Talasemia
Es la especie de mosquito que transmite la malaria
Mosquito anopheles gambiae
Es el estado biológico que presenta plasmodium al encontrarse en las glándulas salivales del mosquito anopheles y picar al huesped
Esporozoito
Sitio de replicación del plasmodium
Hígado
Es el tipo de replicación o reproducción asexual que tiene plasmodium en el huesped
Esquizogonia
Son las especies causantes de malaria que producen sintomatología y enfermedad a las 2 semanas de haber sido infectado el huesped
P. falciparum, p. malariae y p. knowlesi
Son las especies causantes de malaria que quedan senescientes en el hígado por meses a años antes de producir enfermedad
P. vivax y P ovale
Es la forma biológica resultante de la invasión hepática de los esporozoítos de malaria en p. faciparum, p. malariae y p. knowlesi
Merozoítos
Es la forma biológica resultante de la invasión hepática y senescencia que presenta la malaria en p. vivax y p. ovale
Hipnozoítos
Son las especies que generan disfunción hepática importante a las 2 semanas de la infección
P. falciparum, p. malariae y p. knowlesi
Es el nombre que se le da al periodo de la enfermedad donde se inicia la invasión hepática, ya sea replicativa de forma aguda o senesciente
Fase exoeritrocítica (usualmente asintomática)
Especie/s de plasmodium con una afinidad mayor a la infección de reticulocitos
Plasmodium vivax
Especie/s de plasmodium con una afinidad mayor a la infección de eritrocitos de mayor longevidad
P. malariae y knowlesi
Al ver este frotis, uno debe considerar el diagnóstico de _________, ya que se observa el hallazgo característico de__________, lo cual corresponde a la forma biológica dentro del eritrocito llamada _______

- Malaria
- Forma de anillo
- Trofozoíto temprano
Al ver este frotis, uno debe considerar el diagnóstico de _________, ya que se observa el hallazgo característico de__________, lo cual corresponde a la forma biológica dentro del eritrocito llamada _______

- Malaria
- Anillo compacto o forma ameboide
- Trofozoíto tardío (segundo estadio)